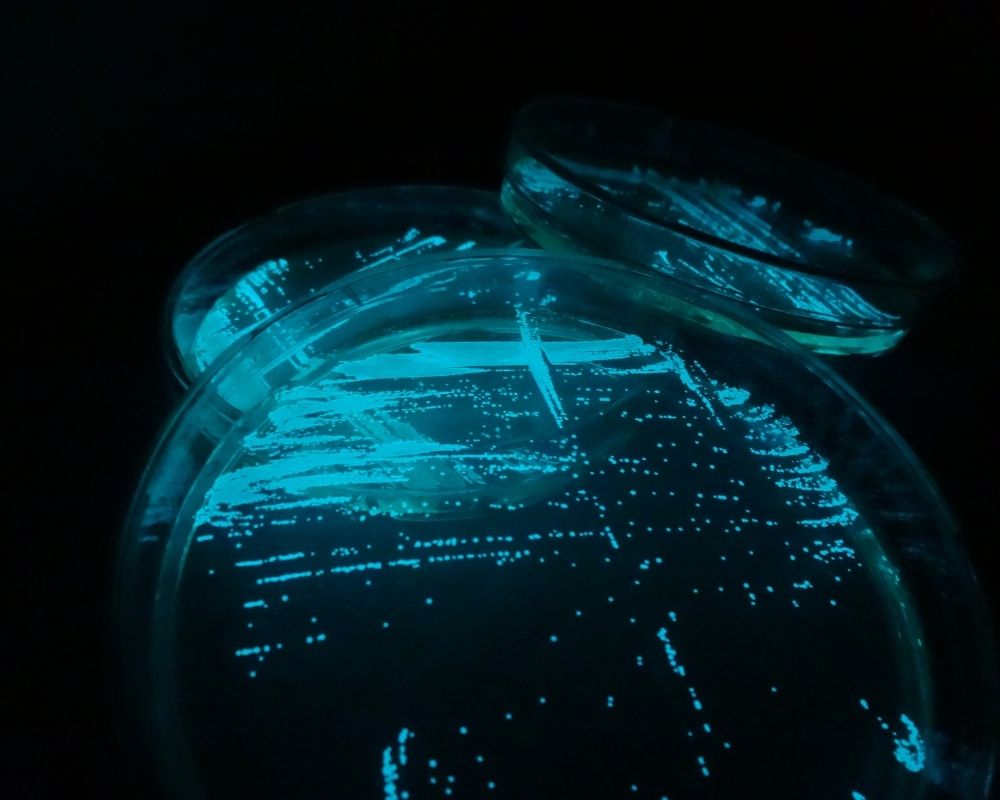

gel bioluminescent
quand la lumière se stabilise et s’observe au repos
le gel, un support de lumière stable
Dans notre pratique, nous utilisons un milieu nutritif solidifié à l’agar-agar, un gélifiant naturel d’origine végétale. Ce support permet aux bactéries de se développer sous forme de colonies fixes, visibles à l’œil nu par leur éclat lumineux.
Ces colonies apparaissent sous forme de points ou de couches lumineux, selon les conditions de croissance et le format du dispositif.
une lumière plus fiable, moins sujette aux pertes
Contrairement aux milieux liquides où la lumière peut fluctuer ou disparaître selon les manipulations, les cultures en gel montrent une meilleure stabilité de la bioluminescence dans le temps.
Lors du repiquage (transfert d’une colonie vers un nouveau support gélosé), la perte de lumière est rarement observée.
Cela s’explique notamment par :
- une sélection visuelle directe des colonies lumineuses
- une meilleure conservation des lignées actives
- une réduction du transfert involontaire de variants non lumineux
un outil de culture… mais aussi d’observation
Le gel devient ainsi un double outil :
- d’un côté, il favorise une croissance maîtrisée
- de l’autre, il permet une lecture immédiate de la lumière : ce qui éclaire est vivant, ce qui s’éteint ne l’est plus.
Il offre aussi un avantage pédagogique et esthétique important : la lumière peut être montrée, cadrée, installée comme une matière vivante.
sphères bioluminescentes : une lumière vivante en volume
Parmi les dispositifs développés à partir du gel bioluminescent, Jérémie Brugidou a conçu des sphères lumineuses (projet « La lumière de la mer »), présentées au public dans le cadre de plusieurs évènements.
Ces sphères transparentes contiennent une fine couche de gel déposée sur la paroi intérieure, tandis que le reste du volume reste rempli d’air.
Ce format présente plusieurs avantages :
- Assez d’oxygène à l’intérieur du contenant pour permettre aux bactéries de respirer
- Une lumière visible à 360°, en volume
- Une bonne tenue dans le temps, sans intervention extérieure
- Ces sphères scellées deviennent des objets vivants autonomes, intégrés dans des contextes artistiques ou naturels.
limites et conditions techniques
Les systèmes gélosés présentent quelques contraintes importantes :
- Ils sont souvent fermés et scellés, ce qui impose de bien doser l’air et les nutriments dès le départ
- Le gel doit adhérer à une surface compatible (verre, plastique, etc.) sans se décrocher
- Le taux d’oxygène dans le contenant doit être suffisant pour permettre l’activité bactérienne : la bioluminescence dépend d’une oxygenation continue
- Il n’est pas possible de “relancer” une culture une fois la lumière éteinte, sans ouvrir et reconditionner l’ensemble
Vous avez une idée ? Un projet ? Envie de faire émerger une expérimentation ? Parlons-en.